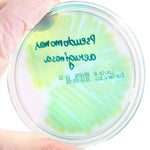

By GMP-SOP-Download Laboratory
USP 62 Absence of Pseudomonas aer
Regular price
£16.99 GBP
Regular price
Sale price
£16.99 GBP
Unit price
per
Tax included.
Shipping calculated at checkout.
Couldn't load pickup availability
SOP and report form for testing the absence of pathogenic Pseudomonas aeruginosa in products according to harmonized methods USP <62> and EP 2.6.13

Regular price
£16.99 GBP
Regular price
Sale price
£16.99 GBP